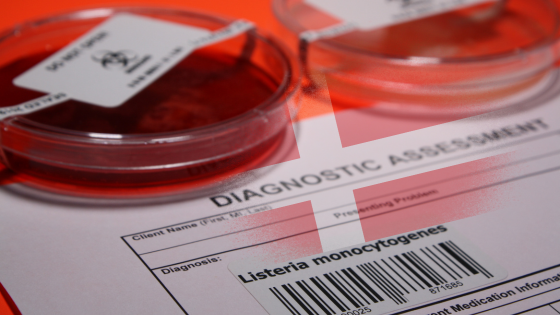

W Stanach Zjednoczonych doszło do ogólnokrajowego wybuchu listeriozy związanego z gotowymi daniami makaronowymi sprzedawanymi w największych sieciach handlowych. Potwierdzono dziesiątki zachorowań, hospitalizacje i zgony, a w efekcie służby sanitarne oraz producenci ogłosili szeroką akcję wycofywania skażonych produktów z rynku.
Nowe ognisko Listeria monocytogenes w Danii: siedem zakażeń potwierdzonych przez SSI
W Danii potwierdzono ognisko inwazyjnych zakażeń Listeria monocytogenes o typie sekwencyjnym 403. Od sierpnia 2025 r. Statens Serum Institut (SSI) zarejestrował siedem przypadków zachorowań. Dochodzenie prowadzone jest wspólnie przez SSI, Duńską Administrację Weterynaryjną i ds. Żywności (Fødevarestyrelsen) oraz Narodowy Instytut Żywności przy Duńskim Uniwersytecie Technicznym (DTU Fødevareinstituttet).
Charakterystyka ogniska
Między 21 sierpnia a 24 października 2025 r. odnotowano siedem przypadków zakażeń tym samym szczepem Listeria monocytogenes. Wśród pacjentów było pięć kobiet i dwóch mężczyzn. Chorzy to przede wszystkim osoby starsze, w wieku od 75 do 99 lat, przy medianie 84 lat. Zachorowania zgłoszono w różnych regionach kraju: cztery w Hovedstaden, dwa w Syddanmark oraz jedno w Sjælland.
Przebieg dochodzenia
Ognisko jest analizowane przez Centralną Grupę ds. Ognisk Chorób Zakaźnych, w której skład wchodzą SSI, Fødevarestyrelsen oraz DTU Fødevareinstituttet. SSI odpowiada za sekwencjonowanie całogenomowe izolatów Listeria monocytogenes pobranych od pacjentów oraz za prowadzenie wywiadów epidemiologicznych z chorymi lub ich bliskimi. Celem tych działań jest identyfikacja potencjalnej drogi zakażenia lub źródła żywnościowego.
Wyniki analiz laboratoryjnych
Analizy laboratoryjne prowadzone przez Statens Serum Institut obejmowały sekwencjonowanie całogenomowe izolatów Listeria monocytogenes pobranych od wszystkich siedmiu pacjentów. Badania wykazały, że szczepy są ze sobą bardzo blisko spokrewnione pod względem genomowym i należą do typu sekwencyjnego 403. Uzyskane wyniki wskazują na wysokie podobieństwo genetyczne pomiędzy izolatami, co sugeruje, że zakażenia mogą być powiązane i stanowić część tego samego ogniska. Sekwencjonowanie całogenomowe stanowi w tym przypadku kluczowe narzędzie wspierające powiązanie przypadków oraz dalsze prowadzenie dochodzenia epidemiologicznego.
Podsumowanie
Listeria monocytogenes jest szczególnie niebezpieczna dla osób starszych, osłabionych, przewlekle chorych oraz kobiet w ciąży. Duńskie służby przypominają o podstawowych zasadach zmniejszających ryzyko zakażenia, takich jak spożywanie produktów gotowych do spożycia w możliwie jak najświeższej formie, utrzymywanie odpowiedniej temperatury chłodniczej czy unikanie surowego mleka i miękkich serów z mleka niepasteryzowanego. Ognisko pozostaje w trakcie dochodzenia, a zaangażowane instytucje kontynuują działania mające na celu ustalenie źródła zakażenia i zapobieganie kolejnym przypadkom.
Źródło: SSI
Przeczytaj także
-
 18.11.2025
18.11.2025
Nowe badanie wskazuje na możliwość wielokrotnego wzrostu zdolności tworzenia biofilmu przez Listeria monocytogenes
Czytaj więcejNowo opublikowane badanie eksperymentalne pokazuje, że Listeria monocytogenes może w krótkim czasie wykształcić warianty o znacznie zwiększonej zdolności tworzenia biofilmu. Odkrycie to rzuca nowe światło na mechanizmy przetrwania patogenu w środowisku produkcji żywności.
-
 14.11.2025
14.11.2025
Śmiertelne ognisko listeriozy w USA – skażone dania makaronowe przyczyniły się do sześciu zgonów
Czytaj więcej -
 10.11.2025
10.11.2025
Salmonella Serovar Wiki: Nowe narzędzie wspierające zarządzanie ryzykiem mikrobiologicznym
Czytaj więcejCornell Food Safety Laboratory opracowało Salmonella Serovar Wiki – ogólnodostępną platformę internetową zawierającą usystematyzowane informacje o ponad 100 serotypach Salmonella. Narzędzie to wspiera specjalistów z branży spożywczej, służb sanitarnych i środowisk naukowych w szybkim dostępie do danych istotnych dla oceny ryzyka, dochodzeń epidemiologicznych i analizy zagrożeń mikrobiologicznych.

.png)
.png)
